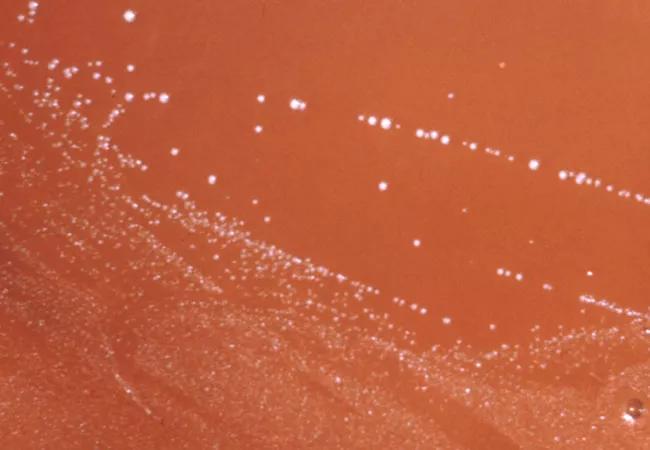

Developing and Optimizing the Severe Sepsis Care Path
Image content: This image is available to view online.
View image online (https://assets.clevelandclinic.org/transform/7625555a-cf99-4acf-94f3-72ac935b7a58/sepsis_650x450_jpg)
sepsis_650x450
Every year, 750,000 Americans are diagnosed with the sepsis. Anyone with an infection can develop sepsis, and it is the most expensive condition treated in hospitals, with an annual price tag of $24 billion, according to the Agency for Healthcare Research and Quality.
Advertisement
Cleveland Clinic is a non-profit academic medical center. Advertising on our site helps support our mission. We do not endorse non-Cleveland Clinic products or services. Policy
Viewed as a three-stage syndrome, sepsis begins with infection, progresses to severe sepsis and leads to septic shock and death. Nearly half of patients who die in U.S. hospitals have sepsis, and the mortality rate for inpatients with severe sepsis ranges from 25 to 50 percent, according to the National Institute of General Medical Services.
In April 2013, Cleveland Clinic President and CEO Toby Cosgrove, MD, called for better sepsis outcomes. “We’re lucky we started when we did,” says Michelle Ferrari, BSN, RN, research manager and care path lead in the Respiratory Institute. Cleveland Clinic was proactive in making sepsis management a priority before guidelines were announced by the Centers for Medicare & Medicaid Services (CMS).
Today, CMS measures include a Severe Sepsis/Sepsis Shock Early Management Bundle (SEP-1). When patients are identified with sepsis, hospitals must document actions taken consistent with bundled expectations that must be completed within 3 and 6 hours. The CMS SEP-1 bundle was initiated with hospital discharges in fiscal year 2016 (Oct. 1, 2015), and performance results are posted on the CMS Hospital Compare website.
The initial Cleveland Clinic severe sepsis care path was completed in July 2013, with Nursing taking an important role in its development. “This project brought together representatives from across our organization—intensive care, internal medicine, emergency services, infection control, pharmacy, laboratory—to look at how we treated sepsis then and how we could implement the Surviving Sepsis Campaign (SSC) guidelines,” says James Bryant, MSN, RN, CEN, CCRN, NEA-BC, Associate Chief Nursing Officer of Emergency Services.
Advertisement
The CMS guidelines (and the care path) include clinical definitions of severe sepsis and septic shock, diagnostic criteria, and 3- and 6-hour management bundles that are consistent with the SSC guidelines and CMS core measures.
The severe sepsis care path testing began with a pilot study in the intensive care units and the emergency departments at Cleveland Clinic’s main campus and Fairview Hospital, where Ferrari and colleagues quickly demonstrated its potential impact. Then, from February through April 2014, hospitals examined outcomes of 8,870 patients. A paper tool guided the clinical decision process, and screening included lactate results as an early identifier of sepsis.
Severe sepsis was diagnosed in 403 patients (4.5%), and 3- and 6-hour bundles were initiated. Compared with the same three months in 2013:
The sepsis team then worked with computer programmers to develop a paperless screening and best-practice alert system in the electronic medical record (EMR). When vital signs are entered, a yellow alert appears on the computer screen if the patient meets two or more criteria for systemic inflammatory response syndrome (SIRS).
“In the ED, if we document abnormal vital signs, we will get an alert asking if there is a concern for sepsis. If we say ‘yes,’ we are directed to call the physician and get an order for a lactate level,” says Bryant. If the lactate is higher than normal, the nurse informs the physician, and they begin the sepsis bundle (3- or 6-hour, based on acuity).
Advertisement
After being tested on seven medical floors, the best-practice alert system was rolled out to ICUs, EDs, and appropriate medical floors in all Cleveland Clinic hospitals, says Ferrari. This standardized approach helped to align sepsis management throughout Cleveland Clinic. “The process was more challenging than expected, but it brought to light some technologies the hospitals needed,” says Ferrari.
Because the signs and symptoms of sepsis can be subtle or mimic other illnesses (such as pain or tachycardia), the greatest barrier to timely management is delayed identification. “Nurses spend the most time at the bedside. We see subtle signs: a rising temperature, changes in serum laboratory values, patient complaints and patient appearance. Now, we’re able to leverage our EMR system to help identify those signs and symptoms faster,” Bryant says.
In 2015, another pilot on a Cleveland Clinic main campus general internal medicine floor was initiated. New EMR software that was designed to identify sepsis even more rapidly was tested. “We’ve had successes on our unit because we were able to intervene quickly and did not have to transfer patients to the ICU,” says nurse manager Jared Leal, BSN, RN.
When vital signs are entered and a patient meets two or more SIRS criteria, an alert appears on every nurse’s computer on the unit. A countdown timer is activated on the pre-login screen, and a pager carried by the charge nurse or assistant nurse manager receives a “code sepsis” alert.
The nurse then pages the physician for a decision on whether or not to draw a lactate level. “If the physician decides yes, we consider sepsis as a diagnosis, and we partner with an adult medical emergency team—a physician, an RN and a respiratory therapist,” says Leal.
Advertisement
The respiratory therapist brings a point-of-care machine to the bedside, a nurse draws a lactate level and then receives the result in seconds. “This is phenomenal, because we have only three hours to complete the bundle,” Leal says.
Based on experience with 10 patients with sepsis since October, Leal says proceeding with all interventions in the bundles is too much for one primary nurse. “We learned that it takes the entire nursing team working together to implement all interventions within the allotted time,” he says.
Every Cleveland Clinic care path is a dynamic document intended to be updated. “Our sepsis group is still meeting every week. We look at the data that’s been collected, at how well the process is working, and what we need to do to make refinements,” says Bryant.
“We have the best chance of detecting sepsis early and intervening quickly with antibiotics and fluids when everyone follows the same course of action,” he adds. “Reducing mortality is our goal, and people are becoming more comfortable with the protocols as they use them.”
Sepsis affects all age groups. Especially vulnerable are newborns, young children and the elderly. People at increased risk include adults with chronic illnesses such as diabetes, cancer, AIDS, kidney or liver disease, pregnant women; and people who have experienced a severe burn or physical injury.
Advertisement
Source: Sepsis Fact Sheet. World Sepsis Day, Sept. 13, 2015
Photo credit: Centers for Disease Control and Prevention
Advertisement
Nurses play key role in comprehensive lifetime treatment program
Customized bots improve speed, efficiency by streamlining daily clinical, clerical tasks
Nurses play pivotal role in patients’ ability to recover in the comfort of their own homes
New protocol reduces costs, increases patient and caregiver satisfaction
Advocating for patient safety is imperative in fast-paced surgical settings
M-Power program improves the perinatal experience for people who have survived abuse
Advice for those pursuing a WOC nursing career
Veteran nurse shares his experience as a caregiver and community volunteer